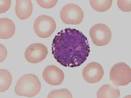
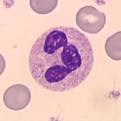

Ce sont des cellules qui possèdent un noyau polylobé, un cytoplasme acidophile qui contient des granulations appelées neutrophiles.
I- Morphologie
1- Fixé et coloré au MGG : c’est une cellule sphérique dont les caractères sont :
- Un noyau polylobé
- Un cytoplasme acidophile qui contient 2 types de granulations :
• Granulations primaires ou azurophiles : de couleur rouge qui sont à la limite de la visibilité, non spécifiques car on les rencontre dans d’autres GB et plus particulièrement dans les cellules jeunes.
• Granulations secondaires ou neutrophiles : de couleur marron, réparties dans la totalité du cytoplasme, spécifiques. Ce sont les plus fines granulations des polynucléaires.
2- ME :
C’est une cellule à organites peu développés et peu nombreux, un centre cellulaire (diplosome + Appareil de Golgi), et surtout des granulations d’aspect différent :
- Granulations en bâton de cloche : allongées
- Granulations finement denses
- Granulations légèrement denses
3- Cytoenzymologie
Les granulations azurophiles contiennent la phosphatase acide, hydrolase acide et la myélopéroxidase, ce sont donc de véritables lysosomes.
Les granulations neutrophiles ne sont pas considérées comme des lysosomes car elles contiennent des lysozymes (qui détruisent les parois bactériennes) et la phosphatase alcaline leucocytaire (PAL)
II- Propriétés des PNN
1. Amiboїsme : c’est l’attitude du polynucléaire de se déplacer comme une amibe en mettant des pseudopodes
2. Diapédèse : propriété que possède le PNN de traverser les capillaires sanguins
Dans le sang circulant on distingue deux compartiments :
- Polynucléaire circulant : qui se trouve dans l’axe des vaisseaux, entrainé par le courant circulatoire.
- Polynucléaire marginé : ce sont les polynucléaires qui adhèrent à la paroi capillaire. Ce sont là qui vont subir la diapédèse grâce à l’émission des pseudopodes.
Il existe des facteurs qui favorisent la migration comme l’histamine qui provoque un ralentissement de la circulation et une dilatation du capillaire.

En effet, le passa ge du PNN dans le tissu conjonctif est dû au chimiotactisme. Par Ex, lors d’une infection au niveau de la peau, les bactéries vont produire des substances bactériennes chimiotactiques qui attirent le PNN vers le tissu détruit
3. Phagocytose : le PNN phagocyte essentiellement les bactéries. Elle se fait en plusieurs stades :
- Attachement : la bactérie adhère au PNN dans des sites spéciaux
- Englobement : la bactérie va se trouver dans une vacuole d’endocytose
- La bactéricidie : permet de la tuer
- Digestion : qui se fait grâce aux lysosomes
La phagocytose est favorisée par opsonisation. Quand la bactérie pénètre dans l’organisme, elle entraine la production d’anticorps qui se fixent sur les protéines membranaires de la bactérie ce qui permet la formation de complexe Ag-Ac.
Ce sont des cellules qui possèdent un noyau polylobé, un cytoplasme acidophile qui contient des granulations appelées neutrophiles.
I- Morphologie
1- Fixé et coloré au MGG : c’est une cellule sphérique dont les caractères sont :
- Un noyau polylobé
- Un cytoplasme acidophile qui contient 2 types de granulations :
• Granulations primaires ou azurophiles : de couleur rouge qui sont à la limite de la visibilité, non spécifiques car on les rencontre dans d’autres GB et plus particulièrement dans les cellules jeunes.
• Granulations secondaires ou neutrophiles : de couleur marron, réparties dans la totalité du cytoplasme, spécifiques. Ce sont les plus fines granulations des polynucléaires.
2- ME :
C’est une cellule à organites peu développés et peu nombreux, un centre cellulaire (diplosome + Appareil de Golgi), et surtout des granulations d’aspect différent :
- Granulations en bâton de cloche : allongées
- Granulations finement denses
- Granulations légèrement denses
3- Cytoenzymologie
Les granulations azurophiles contiennent la phosphatase acide, hydrolase acide et la myélopéroxidase, ce sont donc de véritables lysosomes.
Les granulations neutrophiles ne sont pas considérées comme des lysosomes car elles contiennent des lysozymes (qui détruisent les parois bactériennes) et la phosphatase alcaline leucocytaire (PAL)
II- Propriétés des PNN
1. Amiboїsme : c’est l’attitude du polynucléaire de se déplacer comme une amibe en mettant des pseudopodes
2. Diapédèse : propriété que possède le PNN de traverser les capillaires sanguins
Dans le sang circulant on distingue deux compartiments :
- Polynucléaire circulant : qui se trouve dans l’axe des vaisseaux, entrainé par le courant circulatoire.
- Polynucléaire marginé : ce sont les polynucléaires qui adhèrent à la paroi capillaire. Ce sont là qui vont subir la diapédèse grâce à l’émission des pseudopodes.
Il existe des facteurs qui favorisent la migration comme l’histamine qui provoque un ralentissement de la circulation et une dilatation du capillaire.
En effet, le passa ge du PNN dans le tissu conjonctif est dû au chimiotactisme. Par Ex, lors d’une infection au niveau de la peau, les bactéries vont produire des substances bactériennes chimiotactiques qui attirent le PNN vers le tissu détruit
3. Phagocytose : le PNN phagocyte essentiellement les bactéries. Elle se fait en plusieurs stades :
- Attachement : la bactérie adhère au PNN dans des sites spéciaux
- Englobement : la bactérie va se trouver dans une vacuole d’endocytose
- La bactéricidie : permet de la tuer
- Digestion : qui se fait grâce aux lysosomes
La phagocytose est favorisée par opsonisation. Quand la bactérie pénètre dans l’organisme, elle entraine la production d’anticorps qui se fixent sur les protéines membranaires de la bactérie ce qui permet la formation de complexe Ag-Ac.